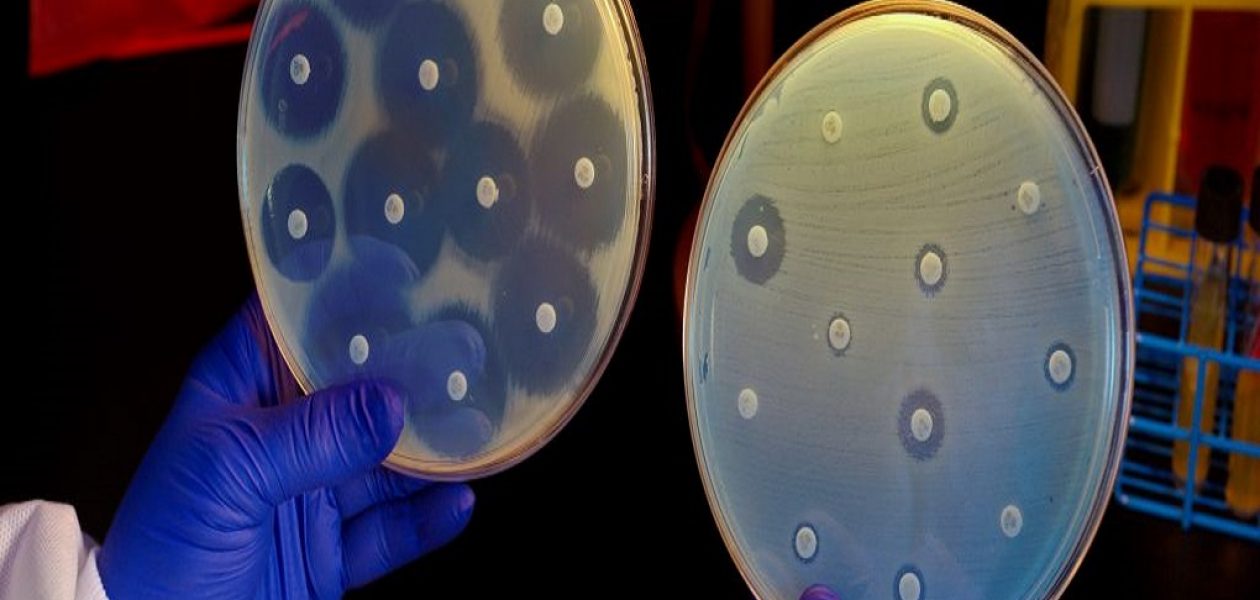

Una bacteria resistente a antibióticos se propaga por el sur del continente europeo.
Un estudio internacional halló una alta incidencia de una bacteria resistente a antibióticos, de la especie Acinetobacter baumannii, a cual se propaga por el sur de Europa. La misma ha sido aislada en pacientes con neumonía asociada a la ventilación mecánica en hospitales de Grecia, Italia y España, según el estudio europeo MagicBullet, que alerta sobre la dificultad de tratar estas infecciones.
De acuerdo con lo reseñado por la agencia internacional de noticias EFE, esta bacteria resistente a antibióticos es una causa importante de infecciones hospitalarias, particularmente en los pacientes ingresados en unidades de cuidados intensivos.
El doctor Jordi Vila, coautor del estudio y director de la Iniciativa de Resistencias Antimicrobianas del Instituto de Salud Global de Barcelona (ISGlobal), señala que debido a la facilidad con la que la bacteria adquiere genes de resistencia, los investigadores han descrito bacterias multirresistentes, extensamente resistentes e incluso resistentes a todos los antibióticos, también llamadas panresistentes.
De las 65 muestras analizadas, todas menos dos eran resistentes a carbapenemos y casi la mitad eran también resistentes a la colistina. Además, ensayos de susceptibilidad antimicrobiana mostraron porcentajes elevados de resistencia a otros antibióticos.
De las 65 muestras, una de cada tres se mostraron panresistentes y no detectaron diferencias en las tasas de resistencia entre los tres países. El análisis molecular indica que la mayoría de las bacterias aisladas pertenecen al mismo linaje, lo que sugiere la existencia de una cepa epidémica que se ha propagado a los tres países, agrega la reseña de EFE.
«Los resultados confirman e incluso superan las estimaciones de resistencia a carbapenems y a colistina en los tres países», advierte Jordi Vila, quien agrega que «la alta incidencia de bacterias aisladas extensamente resistentes y panresistentes subraya la dificultad para encontrar regímenes adecuados para tratar a estos pacientes».